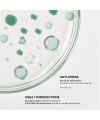
Intensive Anti-Blemish Serum - Patyka I MonCornerB

- New
- Out-of-Stock
Patyka Intensive Anti-Blemish Serum - 30 ml
Organic face serum
The Intensive Anti-Blemish Serum Patyka corrects 7 types of blemishes in 7 days.
Who it's for: Skin in need of a quick solution for pimples, enlarged pores, and excess sebum.
Results: Skin is clearer, pores are tightened, and shine is visibly reduced.
Why we love it: Its 10% PHA + Bakuchiol duo acts quickly without irritating the skin.
Same day shipping for every order placed before noon
See conditionsFree shipping in France from 65€ purchase
Returns are made easy
See conditions Pregnant ? Know more
Pregnant ? Know more
 Comedogenic ? Know more
Comedogenic ? Know more
Patyka's Intensive Anti-Blemish Serum is a micro-peeling treatment that reduces seven types of blemishes. Corrective and preventive, it purifies, smooths skin texture, and regulates excess sebum.
Benefits
Reduces pimples, blackheads, and marks
Tightens pores
Reduces shine
Smoothes irregularities
Limits the reappearance of imperfections
Hydrates and restores suppleness
Key active ingredients
10% PHA (Gluconolactone): gentle exfoliation, micro-peeling effect
Bakuchiol: plant-based alternative to retinol, skin renovator
Zinc Gluconate: regulates sebum
Patented organic lemon balm: limits the impact of skin stress
Hyaluronic acid: moisturizes and smooths
Clinically proven results
91% purified skin in 24 hours*
86% reduction in pimples and blackheads in 7 days*
91% tightened pores in 7 days*
46% reduction in shine after 28 days**
*Consumer test.
**Clinical scoring.
99.9% of the total ingredients are of natural origin.
35% of the total ingredients are from Organic Farming.
COSMOS ORGANIC certified by Ecocert Greenlife according to the COSMOS standard.
INGREDIENTS: AQUA (WATER), MENTHA VIRIDIS (SPEARMINT) LEAF EXTRACT*, GLUCONOLACTONE, GLYCERIN, PENTYLENE GLYCOL, C15-19 ALKANE, GLYCERYL STEARATE, TRIETHYL CITRATE, ZINC GLUCONATE, MICROCRYSTALLINE CELLULOSE, SODIUM HYDROXIDE, CETEARYL ALCOHOL, LAUROYL LYSINE, BAKUCHIOL, ALOE BARBADENSIS LEAF JUICE POWDER*, SODIUM HYALURONATE, MELISSA OFFICINALIS LEAF EXTRACT*, XANTHAN GUM, PARFUM (FRAGRANCE), LEVULINIC ACID, SODIUM LEVULINATE, CELLULOSE GUM, TOCOPHEROL, CARVONE**, VANILLIN**, CHLOROPHYLLINCOPPER COMPLEX, MALTODEXTRIN, HYDROLYZED GARDENIA FLORIDA EXTRACT [01-007-2.07]
*Ingredients sourced from Organic Agriculture.
**Natural constituents of the aromatic composition.
This list of ingredients is subject to change, please consult the packaging of the product purchased.
Questions
Be the first to ask a question about this product!